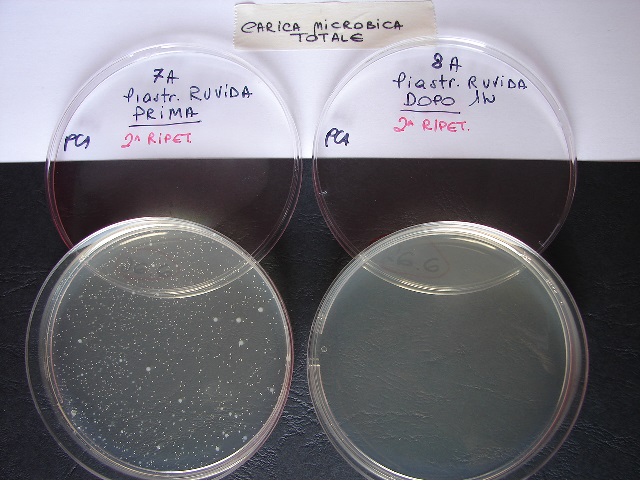
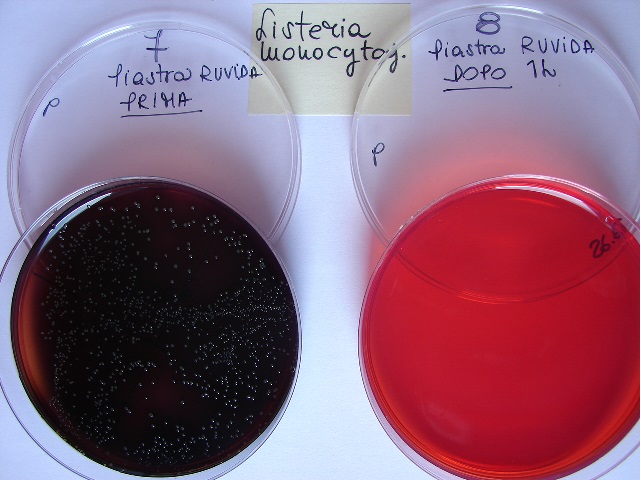

Evaluarea eficientei sistemului Evo- Innovation al TiO2 aplicat pe rasini pentru pardoseala outdoor
INTRODUCERE
Sistemul testat Evo- Innovation actioneaza pe principiul fotocatalizei.
Suprafetele tratate sunt imbracate cu dioxid de titan din punct de vedere fotocalitic activ, TiO2 care atunci cand este expus la lumina formeaza radicali reactive ale oxigenului. Aceasta reactie a oxigenului determina decompozitia moluculelor si a substantelor organice care intra in contract cu suprafata.
Reactia este determinata de expozitia la lumina natura si diurna a suprafetei supusa tratamentului.
Dioxidul de titan este o pulbere cristalina incolora.
Dispersand aceasta substanta pe o suprafata, prin metoda de sprayere, se genereaza un invelis inodor si incolor.
Stratul peliculei este de circa 0,4 micron ceea ce asigura o uscare rapida.
Este posibila tratarea oricarui tip de suprafata fie interioara cat si exterioara.
Evo-Innovation este deci o tehnologie inovativa care , exloatand actiunea catalizatoare al TiO2 care este expus la lumina dezvolta un efect radical ce determina degradarea prin oxidarea numerosilor compusi organici.
Acestui sistem documentat prin studii efectuate in prealabil i-au fost recunoscute diferite proprietati:
actiune dezinfectanta a suprafetelor;
actiune de autocuratare;
actiune de purificare a aerului;
actiune de neutralizare a mirosurilor.
SCOPUL
Studiul a fost realizat cu scopul de a obtine date aferente capacitatii sistemului Evo-Innovation de a determina reducerea sarcinilor microbiene pe rasini ce sunt utilizate pentru pardoseli outdoor, contaminate cu diferite microorganisme.
Folosit cu precadere in structuri medico-sanitare ,pentru care de altfel sistemul a fost proiectat si realizat si convenit principiul de functionare a dispozitivului, si a fost considerat interesanta aprofundarea capacitatii tehnologiei Evo-Innovation de a genera o diminuire a incarcaturilor micorbiene pe placi de gresie exterioara cu scopul de a verifica posibilitatea utilitatii acetui tip de tehnologie in diverse domenii.
MATERIALE SI METODE
Testele au fost efectuate de catre SADVET srl in cadrul laboratorului de teste din Somma Lombardo. Investigatiile analitice au fost conduse de catre acelasi laboratoriu ( acreditat conforme ACCREDIA nr. 0651).
Testele au fost efectuate pe 2 tipuri de rasina, tratate in prealabil cu TiO2 furnizat de catre firma Evopdi Srl:
Rasina pentru pardoseala exterioara pe suprafata neteda (L)
Societatea API- Art. Flexigel decoratiune- synthetic deck flooring ( foto 1);
Rasina pentru pardoseala exterioara pe suprafata striata (R)
Societatea API- Art. Flexigel decoratiune- synthetic deck flooring ( foto 2).
Foto 1 – Rasina API cu suprafata NETEDA

Foto 2 – Rasina API cu suprafata STRIATA
Au fost testate urmatoarele microorganisme si/sau grupuri microbiene:
Incarcatura microbiana totala – CMT,
Pseudomonas spp.,
Mucegaiuri,
Listeria monocytogenes.
Cu scopul efectuarii contaminarii a suprafetelor ce trebuie tratate cu sistemul Evo-Innovation, in zilele anterioare executiei de teste, Laboratorul s-a ocupat de pregatirea Culturilor de microorganisme proaspete, incepand de la microorganisme izolate in special contaminari din mediul inconjurator, folosind:
Brain Heart Infusion- BHI ( pentru bacterii)
Malt Extract Broth ( pentru eumicete).
Prin cultura microorganismelor pregatite s-a efectuat contaminarea suprafetelor destinate testarii.
Acestea au fost asanate in prealabil cu alcool etilic in asa fel incat sa se elimine orice tip de contaminare microbiana ce ar putea interfera.
Poluarea a fost efectuata distribuind, prin intermediul buretelui, cultura de microorganisme sau grupul microbian la nivelul suprafetei.
Pentru fiecare test, contaminarea s-a efectuat pe o zona de circa 200 cm2 ( 2 zone a cate 100 cm2 pentru fiecare- foto 3).
Dupa circa 15 minute ( pentru a lasa se se usuce suprafata), jumatate din zona contaminata a fost supusa controlului: cu ajutorul unui tampon steril, zona a fost curatata cu o perie pentru a verifica gradul real de contaminare a suprafetei ulterior expusa la lumina solara pentru activarea actiunii TiO2.
O data efectuata contaminarea urmata de tamponarea pe portiunea suprafetei destinate controlului de pretratare ( INAINTE), s-a inceput cu expunerea suprafetei la lumina solara pentru o perioada de 60 de minute.
Dupa aceasta perioada s-a continuat cu tamponarea portiunilor suprafetei destinate contrulului de post tratare ( DUPA), cu scopul de a recupera prin curatarea cu ajutorului unui tampon steril microorganismele eventualele microorganisme ce au supravietuit actiunii oxidante dezvoltata de catre actiunea combinata a TiO2 -lumina.
Foto 3- Zona test, inainte si dupa expozitie

INAINTE- arie de 100 cm2 DUPA – arie de 100 cm2
Odata terminat testul pe microorganisme/grupul de microbi, inainte de a executa testul pe diferite microorganisme/grup de microbi, rasina a fost asanata cu alcool etilic.
Acest pasaj garanteaza sterilitatea completa a suprafetei la inceputul fiecarui test dar care nu afecteaza sub nicio forma stratul de TiO2 prezenta la nivelul suprafetei.
Trebuie precizat ca tratamentul Evo-Innovation este rezistent in timp ( garanteaza pana la 10 ani) si nu este activat de substante chimice ( asanare, vopsele) cu care suprafata tratata ar putea intra in contact.
Dupa tehnicile microbiologiei traditionale a fost efectuata numararea microorganismelor prezente pe suprafete inainte si dupa expunerea suprafetelor la lumina solara.
Numararea a fost efectuata folosind medii de cultura adecvate:
TGY Agar ----> Incarcatura microbiana totala – CMT;
Pseudomonas Agar base ----> Pseudomonas spp;
Palcam Agar ----> Listeria monocytogenes;
CGYE Agar ----> Mucegaiuri.
REZULTATE
Sumarul rezultatelor obtinute sunt prezentate in tabelul de pe pagina urmatoare (Tabel 1) in care se evidentiaza valorile de contaminare detectate inainte si dupa expunerea la lumina a celor doua suprafete testate, rasina neteda (N) si rasina striata (S).
Tabel 1 – Sumarul rezultatelor
|
|
Rasina neteda (N) |
Rasina striata (S) |
||||
|---|---|---|---|---|---|---|
|
|
INAINTE DE EXPUNERE |
DUPA EXPUNERE la lumina pentru 60 min
|
INAINTE DE EXPUNERE |
DUPA EXPUNERE la lumina pentru 60 min |
||
|
Microorganism/Tulpina microbiana |
Contaminarea suprafetei-UFC/cm2 |
Contaminarea suprafetei– UFC/cm2 |
||||
|
Incarcatura microbiana totala -CMT (1^ test) |
9,3 x 102 |
< 1 |
8,7 x 102 |
< 1 |
||
|
Incarcatura microbiana totala -CMT (2^ test) |
2,1 x 102 |
< 1 |
1,1 x 102 |
< 1 |
||
|
Pseudomonas spp. |
3,3 x 103 |
< 1 |
1,7 x 103 |
< 1 |
||
|
Listeria monocytogenes |
3,6 x 102 |
< 1 |
4,8 x 102 |
< 1 |
||
|
Mucegaiuri |
1,4 x 102 |
< 1 |
3,0 x 102 |
< 1 |
||
Pe langa cifrele de mai sus care evidentiaza o reducere a incarcaturilor microbiene ale suprafetelor contaminate dupa expunerea la lumina, in scop demonstrativ, vom raporta cateva fotografii ale lamelelor ( foto 5,6,7 si 8).
Lamela aferenta tamponarii pretratate ( INAINTE) constituie '' controlul pozitiv'', si anume confirmarea ca culturile folosite contineau celule vii si vitale cu care s-a efectuat contaminarea suprafetei rasinii tratate cu TiO2.
Lamela aferenta tamponarii post-tratament (DUPA) evidentiaza lipsa cresterii microorganismelor/grupului de microbi dupa incubare, intrucat expunerea la lumina a activat dioxidul de titan care a descompus materialul organic.
Foto 4 – Test pentru CMT pe suprafata neteda

Foto 5 – Test pentru CMT pe suprafata striata
Foto 6 – Test pentru Pseudomonas spp. pe suprafata neteda

Foto 7 – Test pentru Listeria monocytogenes pe suprafata striata
CONCLUZII
Cu privire la testele efectuate de catre Laboratorului SADVET srl ,mai sus amintite, pe rasinile contaminate corespunzator si tratate in exterior cu TiO2 , s-a constatat o actiune bactericida a sistemului Evo-Innovation.
Reducerea incarcaturilor microbiene intalnita este de o importanta semnificativa ( performanta mai buna: reducerea de 3 ordine de marime).
Rezultatele bune permit ipotizarea faptului ca aplicarea sistemului Evo-Innovation ar permite extinderea acestuia spre sectorul de placari exterioare si a diverselor tipuri de utilizare.